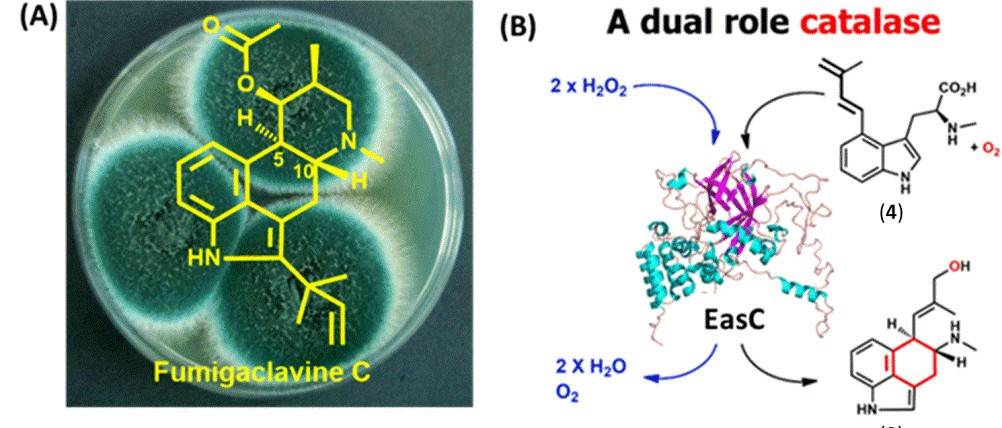
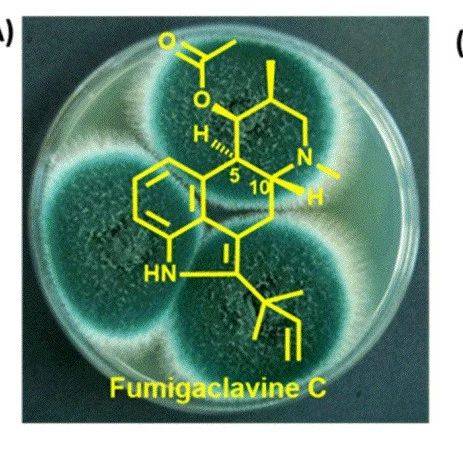

来源:研之成理
双氧水是世界上最重要的化学品之一。它在工业上和日常生活中有着广泛的应用,包括造纸/纸浆业,化学合成,废水处理,医疗消毒等等。目前工业上生产双氧水主要是通过大规模的集中蒽醌循环法。这种方法的问题在于它的能源来自于化石燃料,从而会排放大量的二氧化碳,并产生很多的有机废料和副产物。
现阶段很多研究工作者在致力于通过一种更加绿色和非集中式的方法合成双氧水。其中涉及到的原料仅仅是太阳光,空气和水。具体来说,太阳能在这个过程中被转化成电能,然后在合适催化剂的帮助下,通过电把氧气和水转化成双氧水。在一个典型的电化学反应器中,氧气在正极表面被还原成 HO2- 离子,同时水在负极表面被氧化成氧气,并且释放出氢离子。生成的氢离子和 HO2- 离子结合形成我们需要的双氧水产物。两个电极之间的液态电解质起到了离子导通的作用。
遗憾的是,用这种方法产生的双氧水会和其它离子混在一起,需要复杂且成本高的后续分离步骤,所以并不能直接应用在很多现场就地的应用中。

▲ 共同第一作者:Chuan Xia, Yang Xia;通讯作者:汪淏田
DOI:10.1126/science.aay1844
在最新一期的 Science 当中,莱斯大学的汪淏田课题组设计出了一种可以运用固态电解质连续生产纯双氧水的反应器,从而成功解决了这个难题。简单来说,该设计运用了一种多孔的固态电解质层。它不但能像传统的液态电解质一样有效的传输离子,而且不会溶解于水中,从而不会给产生的双氧水带来任何的离子杂质 (图1b)。

其中正极 O2 被还原成 HO2-,负极通过氢气氧化形成质子 H+。两者分别通过阴离子交换膜和阳离子交换膜移动至中间层结合成 H2O2,再通过中间层的水流将纯产物带出。根据不同的应用,可以通过改变水的流速来产出不同浓度的双氧水。在材料方面,该课题组选用了具有丰富含氧官能团的炭黑作为正极氧还原的催化材料,不但成本低,而且在 200 mA cm-2 的电流密度下选择性高达 90 % 以上,产率高达3660 mol kg-1cat h-1。通过这个新的设计,该课题组成功合成了不同浓度的纯双氧水产物,最高浓度高达 20 %(质量分数)。
该材料和装置还具有高稳定性,运行 100 h 后,材料的活性和双氧水的选择性依然能维持在起始水平(图2 E,F)。为了论证这种方法在废水处理中的潜在应用,该课题组把合成的双氧水产物与休斯顿当地的雨水混合。通过测试,他们发现雨水中的有机污染物含量被成功降到了饮用水标准(2 ppm)以下(图2F),这说明了该设计给世界上那些没有干净饮用水的地区未来提供了一种可能的解决方案。

除此之外,该课题组成功展示了除了 H2 和 O2 以外,负极和整机的原料可以是 H2O 和空气,选择性也可达到 90 % 以上。而且,为了说明该技术在将来规模化产业中的可行性,80 cm2 的 fuel cell 也成功运行。种种结果表明,这种技术将会给世界带来重大变革,为将来的绿色、可持续、非集中式的化学合成铺平道路。特别是在那些没有干净饮用水的地区,通过该设计,人们只要通过空气,水和电,就能轻易得到干净的饮用水。

更多相关内容介绍,请欣赏杭州思斐迩为这篇 Science 制作的动画介绍:
做科研、科普动画,学术封面设计、示意图设计,欢迎联系杭州思斐迩。
来源:rationalscience 研之成理
原文链接:https://mp.weixin.qq.com/s?__biz=MzIwMzE5MzQ1NQ==&mid=2649334227&idx=1&sn=023af1fb60343806b559cefde8d3c53b&chksm=8ece2cd3b9b9a5c5bce4de8918fd459513529ab5ffa861a1af2bcc7716bce878c1935dfa774d&scene=27#wechat_redirect
版权声明:除非特别注明,本站所载内容来源于互联网、微信公众号等公开渠道,不代表本站观点,仅供参考、交流、公益传播之目的。转载的稿件版权归原作者或机构所有,如有侵权,请联系删除。
电话:(010)86409582
邮箱:kejie@scimall.org.cn